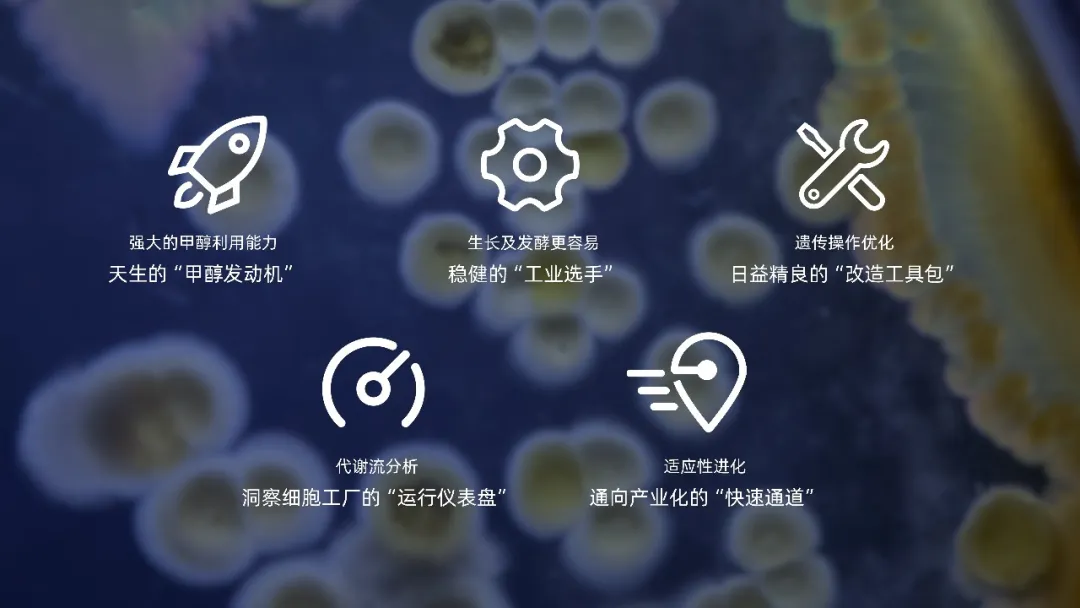

随着绿色能源体系的发展和完善,甲醇不仅可从煤、天然气等传统资源中规模化获得,更可通过捕捉二氧化碳与绿氢催化合成,实现从“碳废物”到“碳资源”的华丽转身,成为连接可再生能源与化学品生产的理想液态载体。虽然化学催化可将甲醇转化为烯烃、芳烃等基础化学品,但对于结构复杂、手性专一的精细化学品,传统化学合成往往步骤繁琐、选择性有限,且依赖贵金属催化剂与苛刻反应条件,既增加了生产成本,也难以满足绿色制造的需求。
而合成生物技术提供了另一种可能:通过设计改造微生物,将其打造为高效利用甲醇的“细胞工厂”,在温和条件下以极高的选择性将甲醇定向转化为特定目标分子,大幅减少副产物与能耗。更重要的是,这一路径可摆脱对亿万年地质积累的化石能源的依赖,转而利用当期可再生能源(如太阳能、风能等)驱动合成的“绿色甲醇”,以及来自大气存量回收或碳循环闭合的二氧化碳,彻底重构化学制造的物质基础,真正实现制造产业的绿色转型。

面临挑战:对于微生物,利用甲醇并非易事
然而,对微生物本身来说,利用甲醇是一道“美食与毒药”的难题。甲醇具有较高的能量密度,其每个碳原子可携带6个电子,相比碳水化合物(每个碳原子携带4个电子)高出50%;这些富余的电子在细胞内可转换为还原力,能显著提升醇类、酸类及脂肪族等目标产物的合成效率。再加上当前甲醇价格已低于葡萄糖,且全球产能持续扩张、成本仍保持下降趋势,“甲醇生物质”这一概念近年来受到了广泛关注与重视,成为一种极具吸引力的发酵底物(或共底物)。但甲醇在微生物体内会被氧化为甲醛、甲酸,而甲醛活性极高,会严重破坏蛋白质和DNA,直接“毒死”细胞。因此,在发酵罐中如何维持甲醇浓度在“既够吃又不致死”的狭窄窗口,成为困扰产业落地的首要工艺难题。
甲基营养类酵母——一类以甲醇为唯一碳源和能量来源的酵母菌,成为解决甲醇浓度控制难题的关键,但这类酵母难以“驯服”,这又成为甲醇生物制造难以逾越的另一道鸿沟。这类酵母虽在甲醇利用中占据天然优势,却犹如难以驯服的“野马”,在遗传与代谢层面存在诸多瓶颈。相较于大肠杆菌等成熟模式生物,甲基营养酵母的遗传背景研究起步较晚,遗传操作工具相对匮乏,基因编辑效率低下、可控表达元件稀缺,这就好比用生僻的编程语言编写复杂代码,不仅工作繁琐,更难以实现精准调控。更深层次的挑战在于其代谢网络的复杂性:微生物的本能是将碳源和能量优先用于自身生长繁殖,而非大量合成目标产物;其代谢路径犹如一座错综复杂的立交桥,如何将甲醇的碳流精准“引导”至目标产物的合成通道,同时关闭或弱化无关代谢支路、减少能量浪费,成为代谢工程领域必须解决的核心难题。
在甲醇生物制造的诸多困境中,一种历经百年深耕的酵母菌株,逐渐成为破解难题的关键——它就是汉逊酵母。一场跨越一个多世纪、环环相扣的科学接力,见证了汉逊酵母从被发现到被优化,最终成为甲醇生物制造核心菌株的全过程,也印证了其作为甲醇生物制造发展方向的核心价值。
汉逊酵母的发现与研究最早可追溯至19世纪。1883年,丹麦科学家埃米尔·克里斯·汉逊(Emil Chris Hansen)博士从嘉士伯酒厂分离出两株酵母菌,一株是啤酒酵母,另一株则被命名为“汉逊酵母”;这一命名沿用至今,成为汉逊酵母百年发展的起点。20世纪初,汉逊酵母开始逐步应用于啤酒酿造和食品工业,科学家们也着手系统研究汉逊酵母在不同环境下的生长规律与代谢功能,其独特的发酵特性在实践中被不断认识和挖掘,为后续针对甲醇利用的深度开发奠定了基础。
近年来,汉逊酵母的研究重心逐步从前期的基础代谢机制探索,稳步转向遗传工具开发、目标产物合成等产业化应用,相关研究热度持续攀升,研究成果呈现爆发式增长。其中,2010年到2020年,关于汉逊酵母甲醇利用方面的研究论文数量迅猛增长,年均增长率约40%,大多聚焦于汉逊酵母甲醇发酵、遗传操作工具优化以及单一目标产物合成技术等领域;2020年之后的研究开始致力于推动汉逊酵母的工业化应用,汉逊酵母相关研究进入爆发式增长阶段,重点围绕目标产物得率提升、多元产品拓展等关键技术展开。目前,甲醇生物制造领域每三篇学术论文中就有一篇聚焦汉逊酵母,该菌株已经成为甲醇生物制造领域的核心研究对象。

如今,随着汉逊酵母改造相关底层技术的不断突破,曾经看似难以实现的甲醇生物制造,正逐步走向产业化。这一系列突破,不仅破解了微生物利用甲醇的核心痛点,更让“以二氧化碳为起点、甲醇为原料生产人类社会所需物质”的绿色制造路径成为可能。

2026年03月06日
Return





